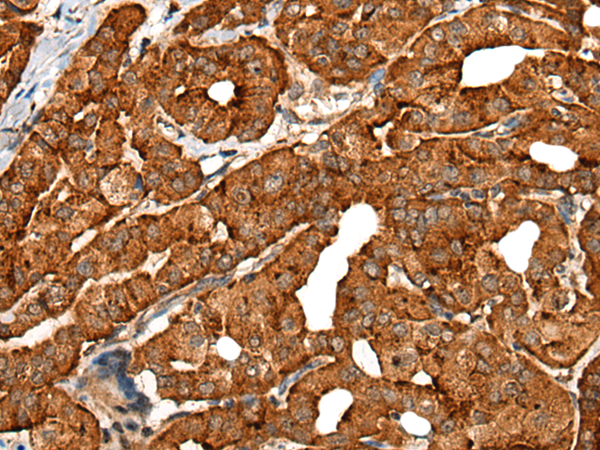

中文名稱:兔抗CDH16多克隆抗體
英文名稱: Anti-CDH16 rabbit polyclonal antibody
別 名: cadherin 16;
相關(guān)類別: 一抗
儲(chǔ) 存: 冷凍(-20℃)
宿 主: Rabbit
抗 原: CDH16
反應(yīng)種屬: Human
標(biāo) 記 物: Unconjugate
克隆類型: rabbit polyclonal
技術(shù)規(guī)格
|
Background: |
This gene is a member of the cadherin superfamily, genes encoding calcium-dependent, membrane-associated glycoproteins. Mapped to a previously identified cluster of cadherin genes on chromosome 16q22.1, the gene localizes with superfamily members CDH1, CDH3, CDH5, CDH8 and CDH11. The protein consists of an extracellular domain containing 6 cadherin domains, a transmembrane region and a truncated cytoplasmic domain but lacks the prosequence and tripeptide HAV adhesion recognition sequence typical of most classical cadherins. Expression is exclusively in kidney, where the protein functions as the principal mediator of homotypic cellular recognition, playing a role in the morphogenic direction of tissue development. Alternatively spliced transcript variants encoding distinct isoforms have been identified. |
|
Applications: |
ELISA, IHC |
|
Name of antibody: |
CDH16 |
|
Immunogen: |
Fusion protein of human CDH16 |
|
Full name: |
cadherin 16 |
|
SwissProt: |
O75309 |
|
ELISA Recommended dilution: |
5000-10000 |
|
IHC positive control: |
Human thyroid cancer |
|
IHC Recommend dilution: |
40-200 |
購物車
幫助
021-54845833/15800441009
